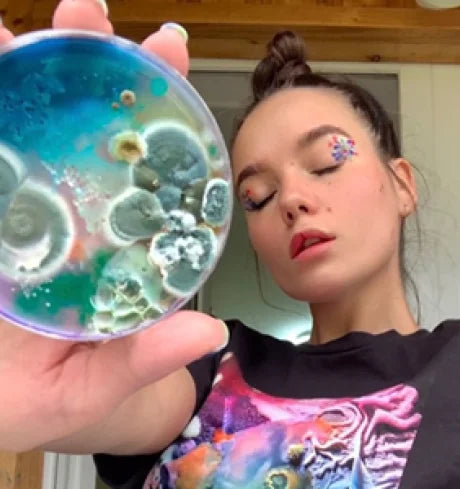
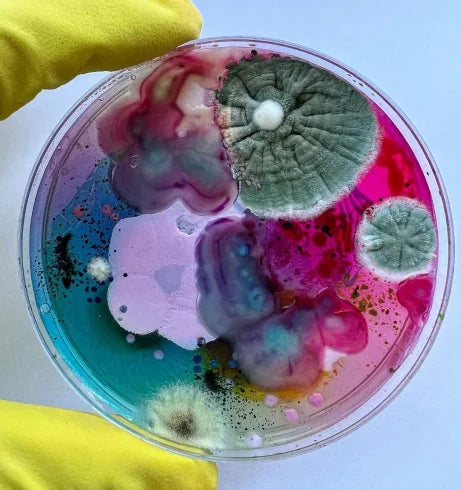
BIO PORTRAIT
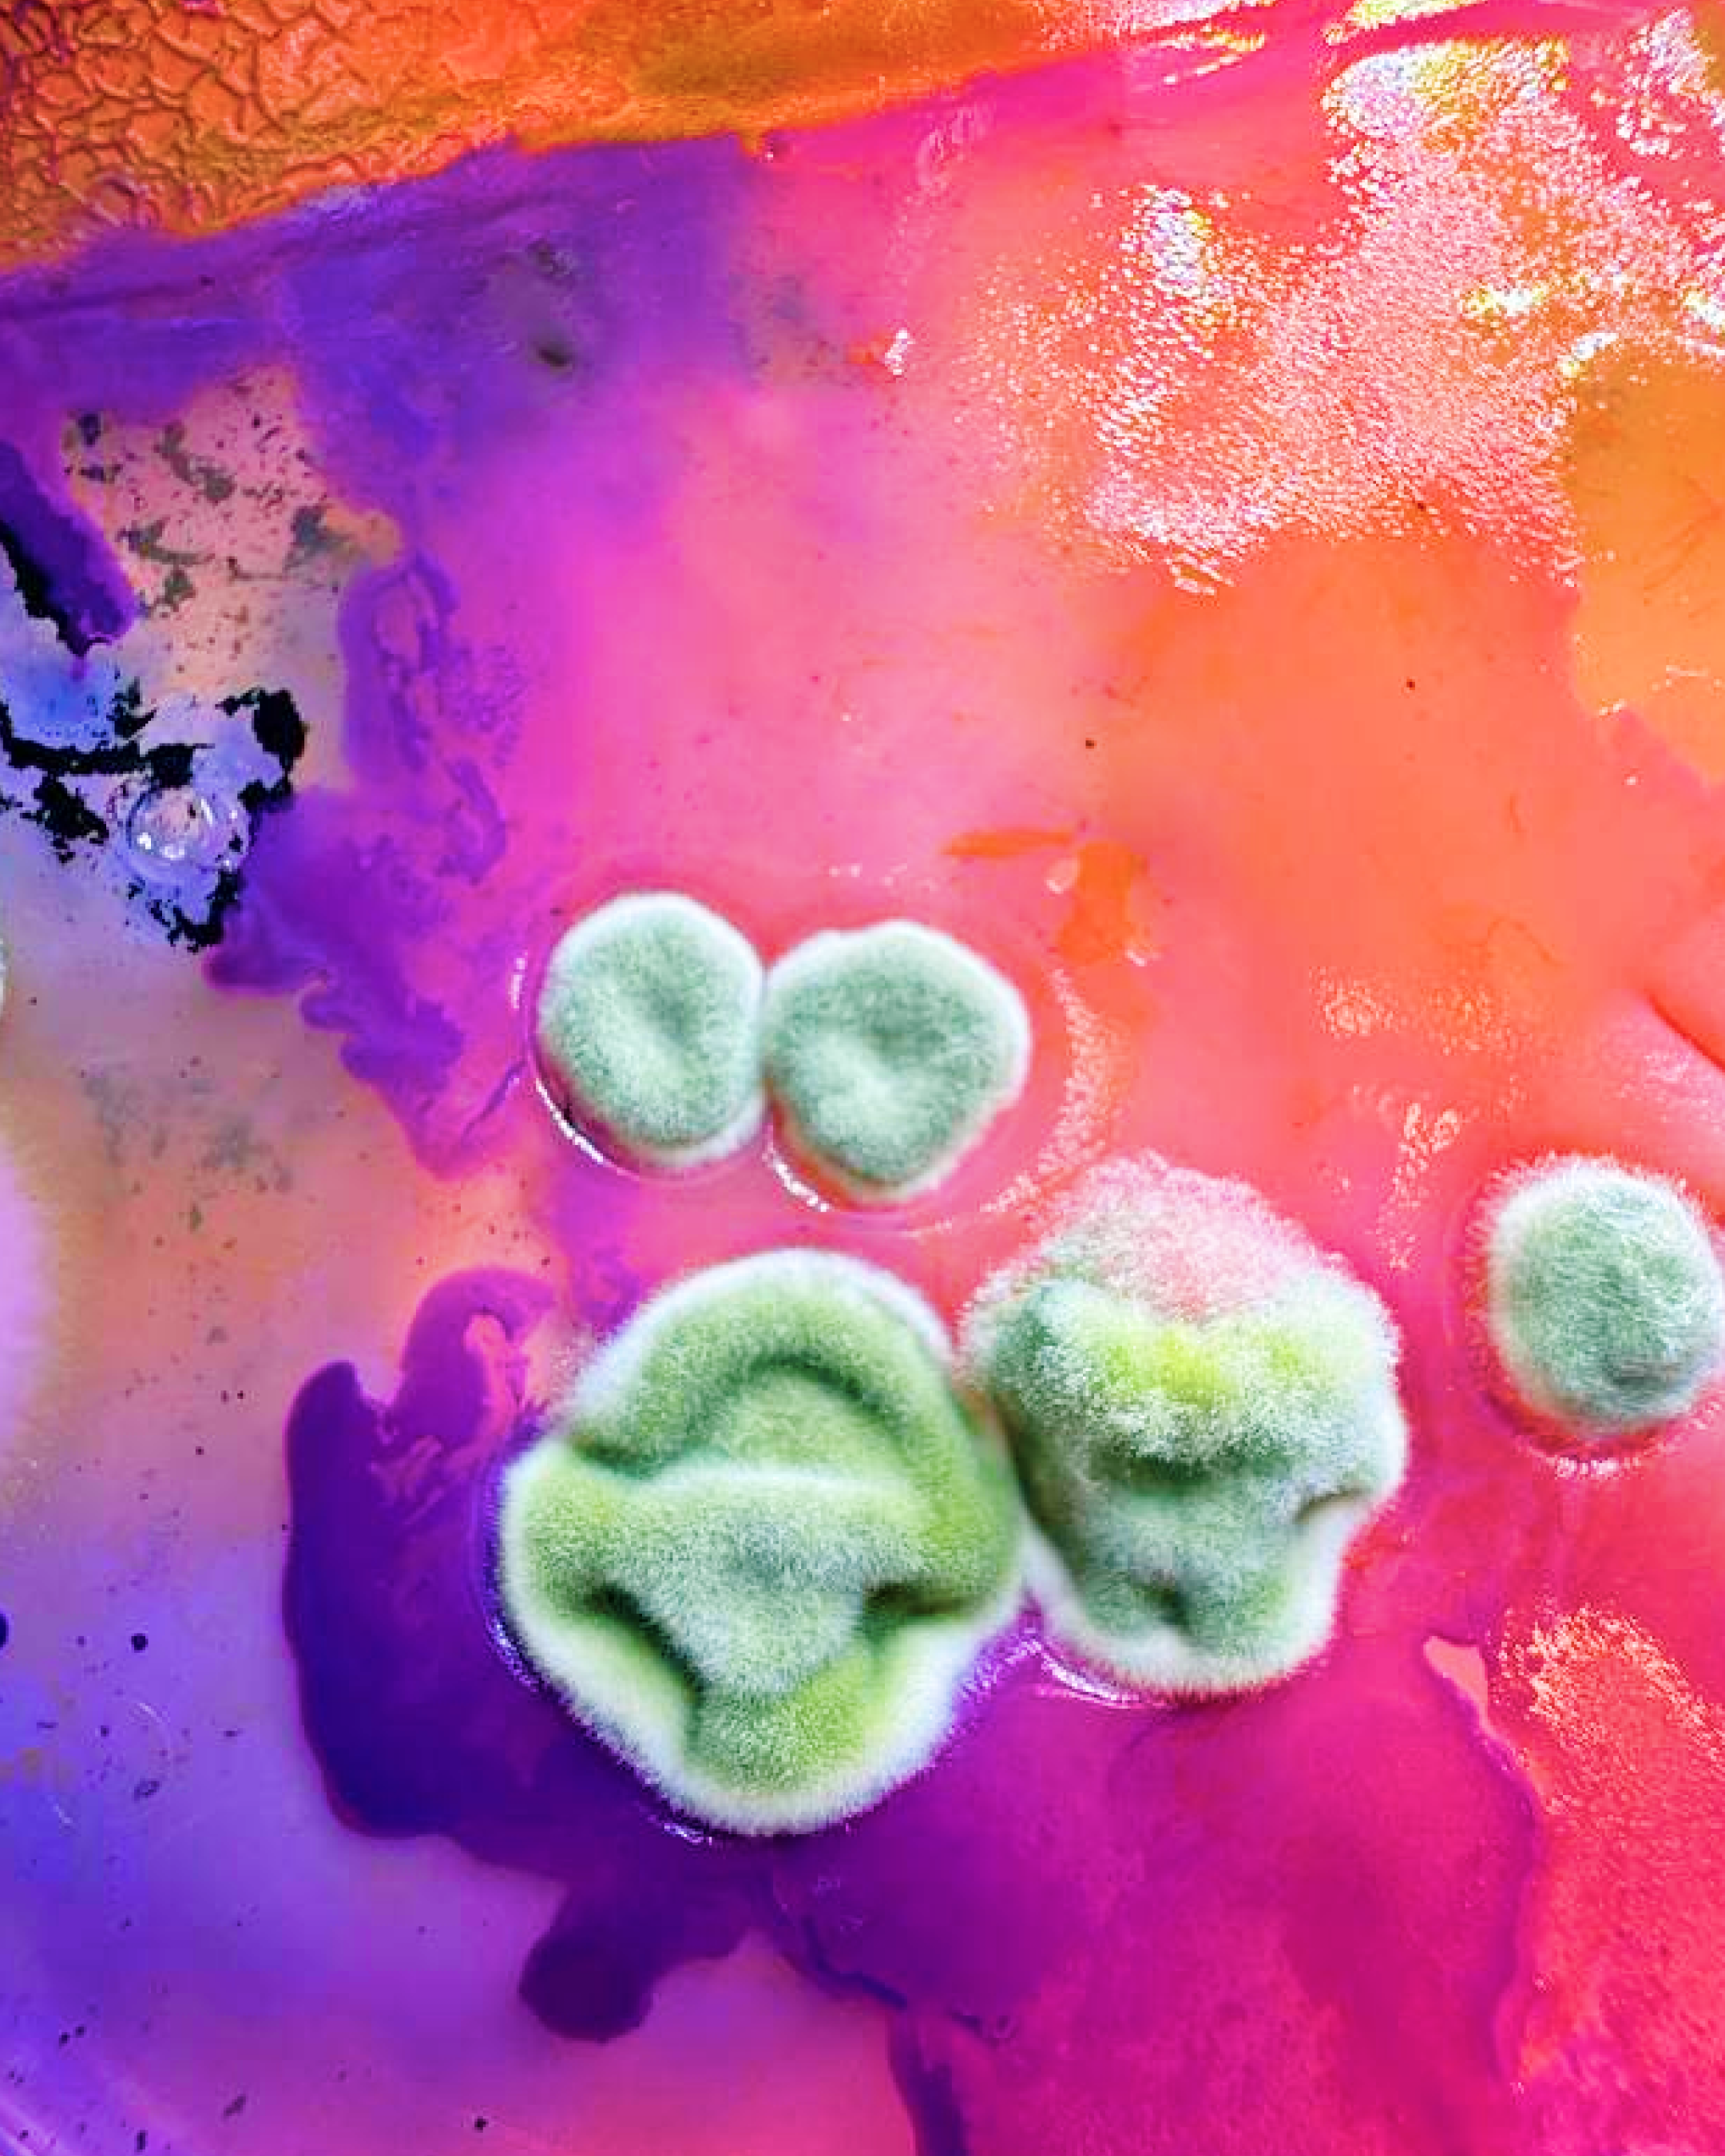

What is a Bioportrait?
Invisible Worlds Becoming Living Portraits
Turning Microbiomes into Masterpieces
Discover
Reveal Hidden Identity
Cultivate
Nature Creates Patterns

Preserve
Seal The Moment
Your Microbiome Turned Into Art

A Portrait Grown From You

Where Science Meets Personal Expression

What People Are Saying
Why Bioportraits Are the Best
Frequently Asked Questions